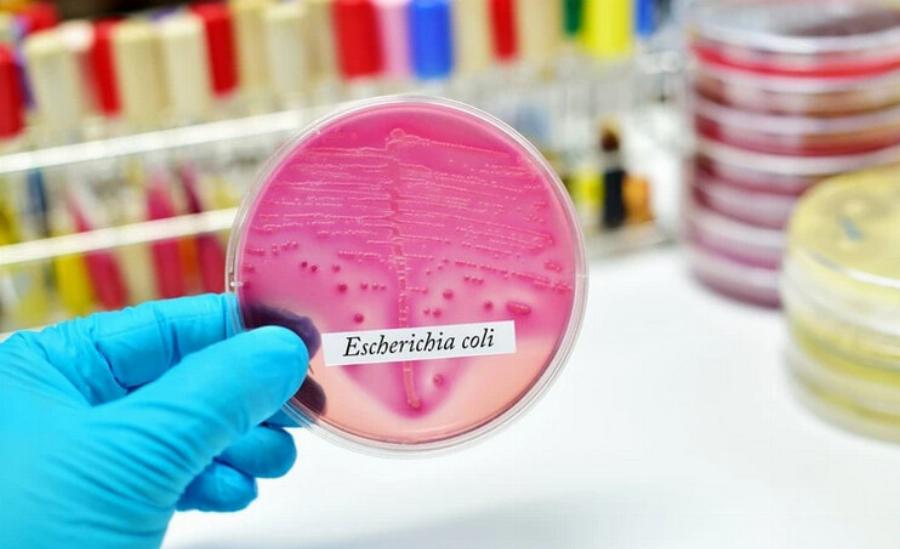
E. Coli στις γάτες: Αιτίες, συμπτώματα & θεραπείες από εγκεκριμένο κτηνίατρο

Το E. coli είναι μια οικογένεια βακτηρίων. Ωστόσο, υπάρχουν πολλοί, πάρα πολλοί τύποι E. coli μέσα στην πολύ μεγάλη οικογένεια βακτηρίων, της οποίας η πλήρης ονομασία είναι Escherichia coli-συντομευμένη σε E. coli. Κάθε τύπος έχει τα δικά του εξελικτικά χαρακτηριστικά.
Ως βακτήριο, το E. coli μπορεί να προκαλέσει λοιμώξεις στα ζώα, και ανάλογα με το πού βρίσκεται η λοίμωξη στο σώμα και τον τύπο του μολυσματικού E. coli, τα σημεία και η κλινική σημασία ποικίλλουν.
Το E. coli μπορεί επίσης να ζει στο σώμα της γάτας χωρίς να προκαλεί λοίμωξη. Διαβάστε παρακάτω για να μάθετε περισσότερα για αυτά τα ποικίλα και ευπροσάρμοστα βακτήρια.

Τι είναι το E. Coli;
Τώρα στις λεπτομέρειες. Το E. coli είναι ένα βακτήριο που ζει στο πεπτικό σύστημα σχεδόν όλων των ζώων, μη παθολογικά, και συνήθως δεν προκαλεί προβλήματα. Ωστόσο, υπάρχουν τρεις κύριοι τρόποι με τους οποίους το E. coli μπορεί να μολύνει τις γάτες.
1. Ένα παθογόνο στέλεχος
Ορισμένοι τύποι E. coli είναι ιδιαίτερα παθογόνοι. Όταν μια γάτα εκτίθεται σε παθογόνο E. coli, μπορεί να αρρωστήσει. Συνήθως, πρέπει να το καταπιούν αφού εκτεθούν στα περιττώματα μολυσμένων ζώων.
Αυτός ο τύπος λοίμωξης από E. coli είναι κοινός σε άλλα είδη κατοικίδιων ζώων, ιδίως στις αγελάδες και τους χοίρους. Ωστόσο, δεν είναι τόσο πολλά γνωστά για το παθογόνο E. coli στις γάτες. Έτσι, ενώ πιθανώς συμβαίνει, δεν έχουν γίνει πολλές έρευνες ειδικά για τις γάτες.
Ωστόσο, αυτός ο τύπος E. coli είναι σημαντικός, διότι εάν μια γάτα έχει παθογόνο E. coli, είναι συνήθως μεταδοτική και μπορεί να μεταδοθεί σε άλλα ζώα και ανθρώπους.
2. Ουροποιητικό σύστημα
Πρόκειται για μια πολύ συχνή λοίμωξη από E. coli στις γάτες, πιο συχνή από το E. coli που προκαλεί προβλήματα στο πεπτικό σύστημα ή άλλες λοιμώξεις. Ένα κατά τα άλλα μη παθογόνο στέλεχος του E. coli εισέρχεται σε ένα μέρος όπου δεν θα έπρεπε να βρίσκεται- το πιο συνηθισμένο μέρος είναι το ουροποιητικό σύστημα. Ένα υγιές ουροποιητικό σύστημα είναι αποστειρωμένο- ωστόσο, εάν εισέλθουν βακτήρια, μπορούν να προκαλέσουν μια ασθένεια: μια ουρολοίμωξη.
Το δέρμα είναι ένα άλλο μέρος όπου το E. coli μπορεί να προκαλέσει μόλυνση, ιδίως όταν υπάρχουν κοψίματα ή εκδορές. Ωστόσο, άλλα βακτήρια τείνουν να είναι πιο συνηθισμένα παθογόνα του δέρματος.
Έτσι, ακόμη και ένα μη παθογόνο στέλεχος του E. coli μπορεί να γίνει παθογόνο σε λάθος σημείο του σώματος.
3. Αδύναμο ανοσοποιητικό σύστημα
Εάν εισέλθει πάρα πολύ E. coli στο σύστημα, μπορεί να υπερφορτωθεί, ειδικά εάν το ανοσοποιητικό σύστημα δεν μπορεί να συγκρατήσει τα βακτήρια. Αυτό συμβαίνει τις περισσότερες φορές στα γατάκια, επειδή το ανοσοποιητικό τους σύστημα αναπτύσσεται ακόμη. Το E. coli προκαλεί σοβαρή διάρροια και επειδή το ανοσοποιητικό σύστημα είναι πολύ αδύναμο, τα βακτήρια εισέρχονται στο σύστημα του αίματος, γεγονός που μπορεί να αποβεί θανατηφόρο. Όταν το πεπτικό σύστημα μολύνεται από E. coli, μερικές φορές ονομάζεται κολιβακίλλωση.

Ποια είναι τα σημάδια του E. Coli;
Τα πιο συνηθισμένα σημάδια μιας λοίμωξης από E. coli στις γάτες είναι τα εξής:
- Επώδυνη ούρηση
- Κόκκινα ούρα
- Ασυνήθιστα συχνή ούρηση
- Ανώμαλα πρότυπα ούρησης
Ωστόσο, εάν το E. coli μολύνει τον πεπτικό σωλήνα, θα προκαλέσει προβλήματα στο πεπτικό σύστημα. Ορισμένα σημάδια του E. coli στον πεπτικό σωλήνα είναι τα εξής:
- Διάρροια
- Αδυναμία
- Αφυδάτωση
- Κατάθλιψη
Ποιες είναι οι αιτίες του E. Coli;
Είναι δύσκολο να γνωρίζουμε ποιος τύπος βακτηρίου προκαλεί μια συγκεκριμένη λοίμωξη, ιδίως χωρίς διαγνωστικές εξετάσεις. Για παράδειγμα, η διάρροια προκαλείται συνήθως και από άλλα βακτήρια όπως:
- Καμπυλοβακτηρίδιο
- Salmonella
- Clostridium
Έτσι, ένα σημαντικό βήμα κατά τη διάγνωση των βακτηριακών λοιμώξεων είναι η εξέταση των βακτηρίων για τον προσδιορισμό της οικογένειας στην οποία ανήκουν.
Αυτό γίνεται με τη δοκιμή καλλιέργειας και ευαισθησίας, όπου τα βακτήρια καλλιεργούνται σε εργαστήριο σε τρυβλία Petri και τα βακτήρια ταυτοποιούνται.
Η σημασία της εύρεσης της αιτίας
Η εξέταση καλλιέργειας και ευαισθησίας ελέγχει επίσης την αποτελεσματικότητα των διαφόρων αντιβιοτικών έναντι των βακτηρίων. Διαφορετικά αντιβιοτικά δρουν καλύτερα κατά του E. coli από άλλα, οπότε η γνώση του τύπου του βακτηρίου βοηθά τους κτηνιάτρους να επιλέξουν το σωστό φάρμακο.
Επιπλέον, η ανθεκτικότητα στα αντιβιοτικά γίνεται όλο και πιο συχνή και αποτελεί όλο και μεγαλύτερο πρόβλημα. Ένα αντιβιοτικό που θα έπρεπε να δρα κατά ενός συγκεκριμένου στελέχους βακτηρίων δεν το κάνει. Έτσι, δεν σκοτώνει τα βακτήρια όταν περιμένουμε να το κάνει-κάνοντας το άσκοπο.
Μια εξέταση καλλιέργειας και ευαισθησίας μας λέει το συντομότερο δυνατό ποια αντιβιοτικά θα δράσουν κατά του συγκεκριμένου στελέχους βακτηρίων της λοίμωξης.
Πώς φροντίζω μια γάτα με E. Coli;
Η συνεργασία με τον κτηνίατρό σας και η διενέργεια των απαραίτητων διαγνωστικών εξετάσεων για τον εντοπισμό του E. coli είναι το καλύτερο που μπορείτε να κάνετε με οποιαδήποτε λοίμωξη από E. coli. Αλλά κάθε τύπος θα απαιτήσει διαφορετική θεραπεία και φροντίδα.
Μια γάτα με λοίμωξη από E. coli σε μέρος του σώματος όπου δεν θα έπρεπε να βρίσκεται (π.χ. ουρολοίμωξη) θα χρειαστεί αντιβιοτικά για τη θεραπεία της λοίμωξης. Κατά προτίμηση, αυτά τα αντιβιοτικά θα επιλεγούν με τη χρήση μιας καλλιέργειας και μιας εξέτασης ευαισθησίας, όπως αναφέρθηκε παραπάνω. Οι περισσότερες από αυτές τις λοιμώξεις μπορούν να αντιμετωπιστούν με εξωτερικά κτηνιατρικά ραντεβού και παρακολούθηση. Ορισμένες ουρολοιμώξεις μπορεί να είναι απογοητευτική η θεραπεία τους και να απαιτούν μεγάλο και εμπλεκόμενο χρονικό διάστημα.
Παθογόνα στελέχη E. Coli
Εάν μια γάτα έχει λοίμωξη από E. coli στο πεπτικό σύστημα, η κατάσταση γίνεται λίγο πιο περίπλοκη. Μπορεί να χρησιμοποιηθούν ή να μη χρησιμοποιηθούν αντιβιοτικά.
Εάν ένα γατάκι έχει σοβαρή διάρροια, θα χρειαστεί πιο εντατική θεραπεία. Φέρτε το αμέσως στον κτηνίατρο. Πιθανόν να χρειαστούν ενδοφλέβια υγρά και υποστηρικτική φροντίδα στο νοσοκομείο για να επιβιώσουν.
Οι ενήλικες με διάρροια μπορεί να είναι σε θέση να αναρρώσουν μόνοι τους ή μπορεί να χρειαστούν κτηνιατρική παρέμβαση. Παρακολουθήστε την άρρωστη γάτα σας και μεταφέρετέ την στον κτηνίατρο εάν δεν βελτιωθεί ή η διάρροια είναι σοβαρή.

Συμπέρασμα
Το E. coli είναι μια ποικιλόμορφη οικογένεια βακτηρίων που μπορεί να προκαλέσει διάφορα προβλήματα στις γάτες. Το πιο συνηθισμένο είναι ως ουρολοίμωξη. Αλλά μπορεί επίσης να προκαλέσει προβλήματα στο πεπτικό σύστημα και να μολύνει σχεδόν οποιοδήποτε μέρος του σώματος, αν του δοθεί η ευκαιρία.
Είναι σημαντικό να βεβαιωθείτε ότι η γάτα σας έχει ένα υγιές πεπτικό σύστημα, ταΐζοντάς την με μια καλά ισορροπημένη διατροφή που σίγουρα δεν είναι μολυσμένη με παθογόνο E. coli.













